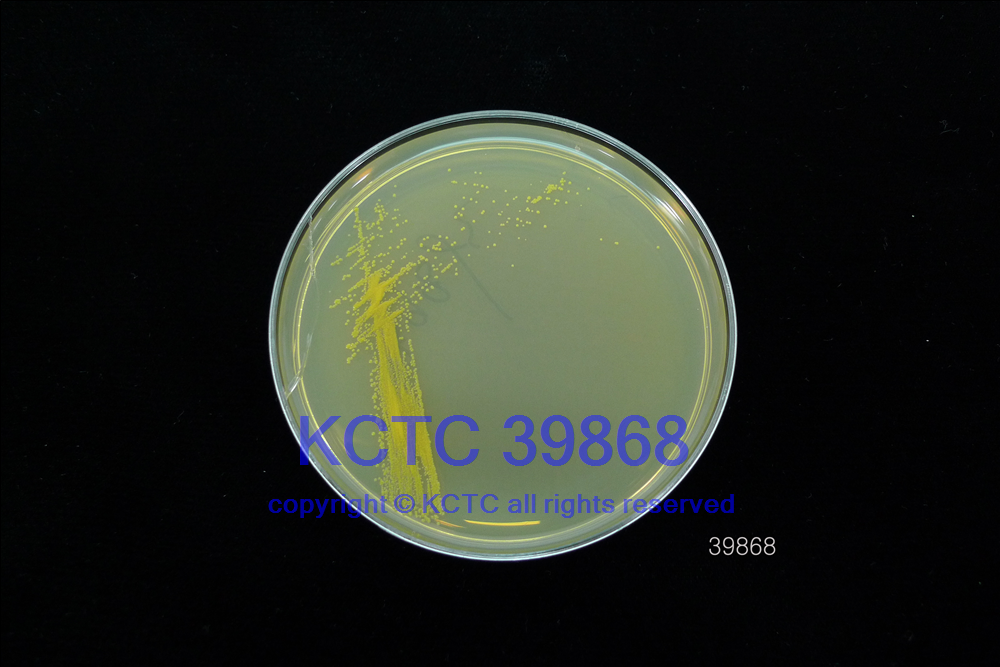

KCTC No. 39868
(KCTC Other No.)
Resource Type Bacteria
Name Corynebacterium lemuris
Type Strain Yes
Biosafty Level 1
LMO No
Synonym
Phylum (ex Phylum) Actinomycetota (Actinobacteria)
Genome Information
History <- Yi JIANG, Yunnan Institute of Microbaiology
Source From animail faeces, Yunnan Wild Animal Park in Yunnan province, south-west China
Other Collection No. YIM 101645, YIM 101645, BCRC [16963], CCTCC [AB 2013281]
Reference 10.1099/ijsem.0.005985
KCTC Media No. KCTC media No. 774 TSA medium
Oxygen Requirement Aerobic
Temperature 28 ℃
pH netural pH ?? ?? (???? ??)